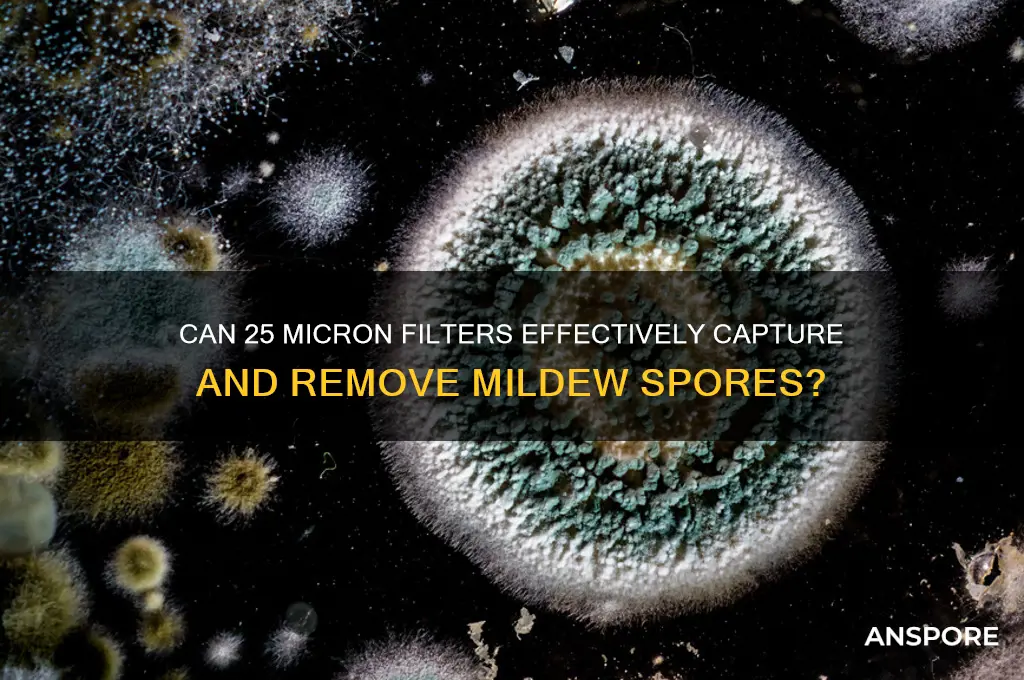
does 25 micron filter mildew spores

The question of whether a 25-micron filter can effectively capture mildew spores is a critical one, especially in industries such as HVAC, food processing, and pharmaceuticals, where air quality and contamination control are paramount. Mildew spores, typically ranging in size from 3 to 30 microns, pose a significant challenge due to their small size and potential health risks. A 25-micron filter, while capable of trapping larger particles, may not be sufficient to reliably capture all mildew spores, particularly those on the smaller end of the spectrum. This limitation raises concerns about the filter's efficacy in preventing mildew-related issues, such as allergic reactions, respiratory problems, and product contamination. Consequently, understanding the capabilities and limitations of 25-micron filters in relation to mildew spore filtration is essential for selecting appropriate air quality solutions.
| Characteristics | Values |
|---|---|
| Filter Size | 25 microns |
| Effectiveness Against Mildew Spores | Limited; mildew spores range from 2-20 microns, so some may pass through |
| Filtration Efficiency | Partially effective for larger particles, but not reliable for spores |
| Recommended Use | General air filtration, not specifically for mildew spore removal |
| Alternative Solutions | Use filters with smaller micron ratings (e.g., 1-5 microns) or HEPA filters |
| Additional Measures | Combine with dehumidifiers, proper ventilation, and mold inhibitors |
| Common Applications | HVAC systems, air purifiers, and water filtration (not spore-specific) |
| Limitations | Does not capture all mildew spores due to size range overlap |
Explore related products
What You'll Learn

Mildew spore size comparison
Mildew spores, typically ranging from 2 to 20 microns in size, are microscopic fungi that thrive in damp environments. To put this into perspective, a human hair averages around 75 microns in diameter, making mildew spores invisible to the naked eye. This small size allows them to easily become airborne and infiltrate HVAC systems, water filters, and indoor spaces. Understanding their dimensions is crucial when evaluating whether a 25-micron filter can effectively capture them.
A 25-micron filter, commonly used in water filtration and some air systems, is designed to trap particles larger than 25 microns. While this may seem sufficient, the majority of mildew spores fall well below this threshold. For instance, a 25-micron filter would allow spores as small as 2 microns to pass through unimpeded. This means that while larger debris and sediment are captured, mildew spores can continue to circulate, potentially exacerbating mold-related issues in homes or industrial settings.
To effectively filter mildew spores, a more precise solution is required. High-Efficiency Particulate Air (HEPA) filters, rated to capture particles as small as 0.3 microns, are far more effective. These filters are commonly used in air purifiers and HVAC systems to combat airborne contaminants, including mildew spores. For water filtration, sub-micron filters or ultraviolet (UV) treatment systems can be employed to neutralize spores, ensuring cleaner and safer water supplies.
When selecting a filtration system, consider the specific application and the spore size distribution. In environments prone to mildew, such as humid basements or greenhouses, combining multiple filtration methods may be necessary. For example, using a 25-micron pre-filter to capture larger particles followed by a HEPA filter can improve overall efficiency and prolong the life of the finer filter. Regular maintenance, including filter replacement and humidity control, is equally vital to prevent spore proliferation.
In summary, while a 25-micron filter serves its purpose in removing larger contaminants, it falls short in trapping mildew spores due to their smaller size. Investing in finer filtration technologies and adopting proactive maintenance practices are essential steps to mitigate mildew-related health risks and maintain indoor air and water quality. Understanding spore size is the first step toward making informed decisions in filtration and environmental control.
Are Spores Always Male? Unraveling the Gender Mystery in Fungi
You may want to see also

Filter efficiency at 25 microns
A 25-micron filter is often considered in the context of capturing particles like mildew spores, but its efficiency hinges on understanding the size of the contaminants in question. Mildew spores typically range from 2 to 20 microns in diameter, which falls within the capture range of a 25-micron filter. However, efficiency isn’t just about size—it’s also about the filter’s design, material, and airflow dynamics. For instance, a pleated 25-micron filter with a larger surface area will trap more spores than a flat filter of the same rating, as it provides more pathways for particles to adhere.
To maximize efficiency, consider the filter’s construction. Synthetic fiber filters often outperform paper or mesh filters at this micron level because they create a more effective barrier. Additionally, electrostatic filters can enhance capture rates by attracting charged particles like mildew spores. Practical tip: Pair a 25-micron filter with a pre-filter to catch larger debris first, reducing the load on the finer filter and extending its lifespan.
Comparatively, while a 25-micron filter can capture mildew spores, it may not be as effective as filters with smaller ratings, such as 5 or 1 micron, which are designed for higher-grade air purification. However, these finer filters can restrict airflow and increase energy consumption, making them less practical for general-purpose applications. A 25-micron filter strikes a balance, offering sufficient protection against mildew spores without significantly impeding airflow.
For optimal results, ensure the filter is properly sealed in its housing to prevent unfiltered air from bypassing the media. Regular maintenance is critical—replace or clean the filter every 3 to 6 months, depending on environmental conditions. In high-humidity areas prone to mildew, more frequent changes may be necessary. Caution: A clogged filter reduces efficiency and can become a breeding ground for spores, so monitor it closely during peak mildew seasons.
Instructively, if you’re using a 25-micron filter in a HVAC system, pair it with dehumidification strategies to address the root cause of mildew growth. Mildew thrives in moisture, so maintaining indoor humidity below 50% complements the filter’s efforts. For DIY applications, such as filtering water or small-scale air purification, ensure the filter’s flow rate matches the system’s requirements to avoid inefficiencies.
Ultimately, a 25-micron filter is a practical choice for capturing mildew spores in moderate-risk environments. Its efficiency depends on proper selection, installation, and maintenance. While it may not rival finer filters in absolute performance, it offers a cost-effective solution for everyday use. Pair it with complementary strategies like humidity control for a comprehensive approach to mildew prevention.
Is Milky Spore Safe for Dogs? A Pet Owner's Guide
You may want to see also

Airborne spore filtration limits
Mildew spores, typically ranging from 2 to 20 microns in size, present a challenge for air filtration systems. A 25-micron filter, while effective against larger particles like dust and pollen, falls short in capturing these smaller spores. This limitation arises from the filter’s pore size, which allows particles under 25 microns to pass through unimpeded. For effective mildew spore filtration, a high-efficiency particulate air (HEPA) filter, rated to capture particles as small as 0.3 microns, is recommended. Such filters operate with an efficiency of 99.97%, ensuring that even the smallest airborne spores are trapped.
Consider the practical implications of using a 25-micron filter in mildew-prone environments, such as basements or bathrooms. While it may reduce visible dust and larger allergens, it fails to address the root cause of mildew-related health issues, such as respiratory irritation or allergies. Mildew spores thrive in damp conditions and can proliferate rapidly, releasing billions of spores into the air. A filter incapable of capturing these spores merely allows them to recirculate, perpetuating the problem. Upgrading to a finer filtration system is not just a technical improvement but a necessary health intervention.
When selecting a filtration system, it’s crucial to match the filter’s capabilities to the specific contaminants present. For mildew spores, a multi-stage filtration approach is ideal. Pre-filters can capture larger particles, extending the life of the HEPA filter, while activated carbon layers can neutralize mold-related odors. Ensure the system is appropriately sized for the space, as inadequate airflow reduces filtration efficiency. For example, a 200-square-foot room requires a filter with a clean air delivery rate (CADR) of at least 150 to effectively reduce spore concentrations.
A common misconception is that running a filtration system intermittently suffices to control mildew spores. However, spores are continuously released, especially in humid environments. Continuous operation of a HEPA filter is essential to maintain air quality. Pairing filtration with dehumidification, keeping indoor humidity below 50%, further inhibits mildew growth. Regular maintenance, such as replacing filters every 6 to 12 months, ensures the system operates at peak efficiency. Ignoring these steps risks turning the filter into a breeding ground for spores rather than a solution.
Finally, while filtration is critical, it’s one component of a comprehensive mildew management strategy. Addressing moisture sources, such as leaks or poor ventilation, is equally important. For instance, fixing a leaky pipe or installing exhaust fans in high-humidity areas prevents mildew from taking hold. Combining these measures with effective filtration creates a synergistic effect, reducing both spore counts and the conditions that foster their growth. In this context, a 25-micron filter is not merely insufficient—it’s a missed opportunity to tackle the problem holistically.
Can Ringworm Spores Float in the Air? Facts and Prevention Tips
You may want to see also
Explore related products

Effectiveness against mildew spread
Mildew spores, typically ranging from 2 to 20 microns in size, are small enough to slip through many filters. A 25-micron filter, while effective against larger particles like dust and pollen, may not consistently capture these spores due to their size variability. For instance, a study on fungal spore filtration found that spores smaller than 10 microns can evade filters with larger pore sizes, highlighting the limitations of a 25-micron filter in mildew control.
To maximize effectiveness against mildew spread, consider pairing a 25-micron filter with additional measures. HEPA filters, rated to capture particles as small as 0.3 microns, are far more reliable for trapping mildew spores. Alternatively, UV-C light systems can be integrated into HVAC systems to neutralize spores mid-air. For practical application, ensure filters are replaced every 1–3 months, depending on environmental humidity and mildew prevalence, to maintain optimal performance.
Comparatively, a 25-micron filter is more suited for pre-filtration, removing larger debris that could clog finer filters. In environments prone to mildew, such as humid basements or greenhouses, relying solely on a 25-micron filter is insufficient. Instead, use it as part of a multi-stage filtration system, combining it with a 5-micron or HEPA filter to achieve comprehensive spore capture. This layered approach ensures that even smaller spores are trapped, reducing the risk of mildew spread.
Persuasively, investing in a higher-grade filtration system is a proactive step toward mildew prevention. While a 25-micron filter offers basic protection, it falls short in high-risk scenarios. For homeowners or facility managers, the added cost of a HEPA or UV-C system is justified by the long-term savings on mildew remediation, which can run into thousands of dollars. Prioritize filtration efficiency to safeguard indoor air quality and structural integrity.
Descriptively, imagine a scenario where mildew spores infiltrate a poorly filtered HVAC system. Over time, these spores settle on damp surfaces, forming unsightly patches that release more spores into the air. A 25-micron filter, though present, fails to halt this cycle, allowing mildew to thrive. In contrast, a well-designed filtration system acts as an invisible barrier, capturing spores before they can take hold, preserving both health and aesthetics.
Why Cheats Don't Work in Spore on Steam: Troubleshooting Guide
You may want to see also

Alternatives to 25-micron filters
A 25-micron filter, while effective for many contaminants, may not reliably capture mildew spores, which can range from 2 to 20 microns in size. This limitation prompts the exploration of alternatives that offer finer filtration or complementary strategies to combat mildew. One such alternative is a High-Efficiency Particulate Air (HEPA) filter, which traps particles as small as 0.3 microns with 99.97% efficiency. HEPA filters are widely used in air purifiers and HVAC systems, making them a practical choice for reducing mildew spores in indoor environments. However, they require regular replacement to maintain effectiveness, typically every 6 to 12 months depending on usage and air quality.
For those seeking a more permanent solution, electrostatic precipitators (ESPs) provide another viable option. These devices use an electric charge to capture particles, including mildew spores, on collector plates. ESPs can filter particles down to 0.1 microns and are particularly effective in industrial or commercial settings. While the initial cost is higher than HEPA filters, ESPs are reusable and require only periodic cleaning of the collector plates. This makes them a cost-effective long-term solution, though they may produce trace amounts of ozone, necessitating proper ventilation.
In addition to filtration systems, ultraviolet (UV) light technology can be employed to neutralize mildew spores directly. UV-C light, with a wavelength of 254 nanometers, disrupts the DNA of microorganisms, rendering them harmless. UV-C lamps can be installed in HVAC systems or used in standalone air purifiers. However, they should not be relied upon as a standalone solution, as they only treat airborne spores passing through the light’s path. Combining UV-C with a HEPA filter or ESP enhances overall effectiveness by ensuring both physical capture and neutralization of spores.
For localized mildew issues, such as in bathrooms or basements, dehumidifiers serve as a preventive measure by reducing moisture levels, which mildew requires to thrive. Maintaining indoor humidity below 50% inhibits mildew growth, complementing filtration efforts. Portable dehumidifiers are suitable for small spaces, while whole-house systems address larger areas. Pairing a dehumidifier with a 10-micron pre-filter can further reduce spore circulation, as pre-filters extend the life of finer filters by capturing larger particles first.
Lastly, natural alternatives like activated carbon filters or essential oils offer supplementary benefits. Activated carbon absorbs volatile organic compounds (VOCs) and odors often associated with mildew, improving air quality. Essential oils such as tea tree or eucalyptus, when diffused in moderation, possess antimicrobial properties that may deter mildew growth. However, these methods should not replace mechanical filtration but rather enhance a comprehensive mildew management strategy. Each alternative has its strengths, and combining multiple approaches often yields the best results in controlling mildew spores effectively.
Streptococcus vs. Coccidioides: Unraveling the Microscopic Similarities and Differences
You may want to see also
Frequently asked questions
A 25-micron filter can capture some mildew spores, but it may not be highly effective since mildew spores are typically smaller, ranging from 2 to 20 microns. Finer filters (e.g., 1-5 microns) are more reliable for spore removal.
Filters with a rating of 1 to 5 microns, such as HEPA filters, are recommended for effectively capturing mildew spores and other airborne particles.
A 25-micron filter may help reduce larger particles but is not sufficient to prevent mildew growth in HVAC systems. Regular maintenance and finer filtration are necessary to control mildew.
Yes, alternatives like HEPA filters, electrostatic filters, or UV-C light systems are more effective for controlling mildew spores and improving indoor air quality.

























